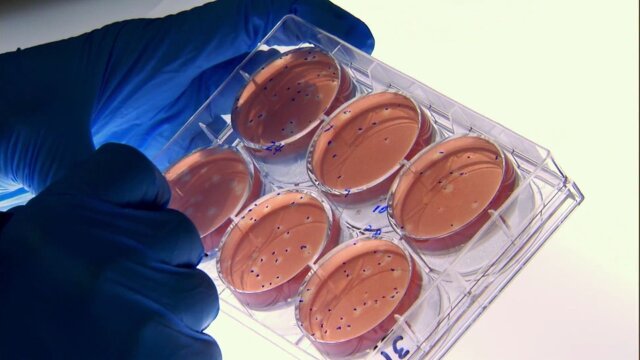

Killer Outbreaks
S1 E5 | Terrorist Within
0h 42m|TVPG|Health, Animals|DLIF|Discovery Life|2011
Soldiers return from the Middle East bringing a mutant bacterium; a severe illness in children.
GENREHealth, Animals
DETAILSNetwork: Discovery Life
Runtime: 42m
Rating: TVPG